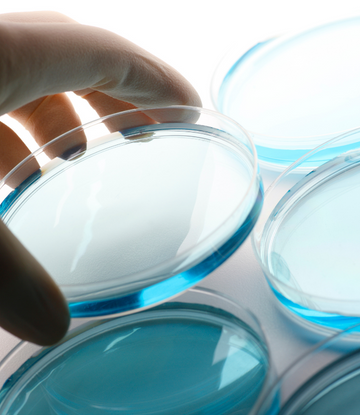

FDA Clears Lab Grown Chicken as Safe to Eat
To compete with conventional meat, cultivated-meat companies acknowledge their product will have to be priced comparably, which will only be possible when they have scaled up production and brought down its costs. Read more about it here.